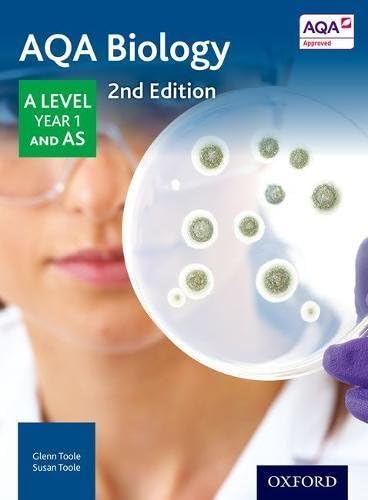
AQA Biology: A Level Year 1 and AS (AQA A Level Sciences 2014)

Buy anything from 5,000+ international stores. One checkout price. No surprise fees. Join 2M+ shoppers on Desertcart.
Desertcart purchases this item on your behalf and handles shipping, customs, and support to Kyrgyzstan.
AQA Biology: A Level Year 1 and AS (AQA A Level Sciences 2014)
Trustpilot
1 month ago
2 months ago
2 weeks ago
2 months ago